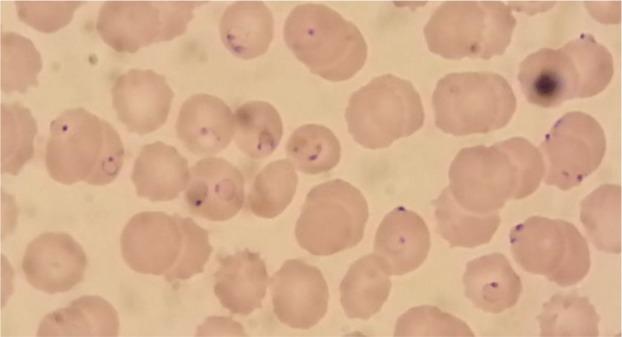
https://cdn.ncbi.nlm.nih.gov/pmc/blobs/6e94/4835461/e8a127b6bdc0/IJPA-11-116-g002.jpg
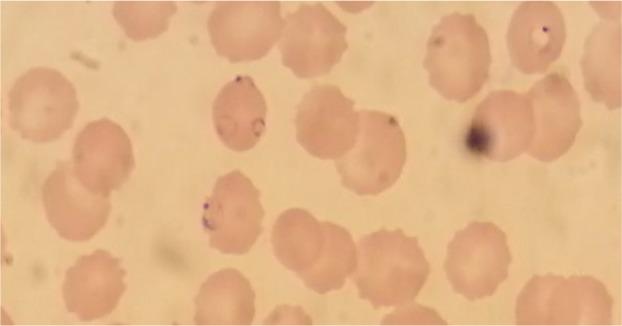
https://cdn.ncbi.nlm.nih.gov/pmc/blobs/6e94/4835461/f726304f5d0b/IJPA-11-116-g003.jpg

重症监护病房中用青蒿素治疗脑型疟疾:一例报告
Cerebral Malaria Treated with Artemisinin in the Intensive Care Unit: A Case Report.
作者信息
Çizmeci Elif Ayşe, Kelebek Girgin Nermin, Ceylan Ilkay, Tuncel Tekin, Alver Oktay, Akalin Emin Halis
机构信息
Department of Anesthesiology and Intensive Care, School of Medicine, Uludag University, Bursa, Turkey.
Department of Infectious Diseases, School of Medicine, Uludag University, Bursa, Turkey.
出版信息
Iran J Parasitol. 2016 Jan-Mar;11(1):116-20.
Malaria is a parasitic disease that is starting to be encountered in intensive care units (ICU) worldwide, owing to increasing globalisation. Severe malaria caused by Plasmodium falciparum, is characterised by cerebral malaria, acute renal failure, hypoglycaemia, severe anaemia, splenomegaly and alveolar oedema. We present the case of a 25-yr old male patient who presented to the Emergency Department of Uludag University in Bursa, Turkey in the winter of 2014 with complaints of fever for three days. His medical history revealed a 14-month stay in Tanzania. Staining of blood smears revealed characteristic gametocytes in accordance with P. falciparum infection. The day after admission, he had an epileptic seizure after which his Glasgow Coma Scale was 6, so he was intubated and transferred to the ICU. A computerized tomography scan revealed findings of cerebral oedema. Intravenous mannitol was administered for 6 days. Intravenous artemisinin was continued for 10 days. Due to refractory fevers, anti-malarial treatment was switched to quinine and doxycycline on the 14th day and on the 16th day the fevers ceased. This case emphasizes that cerebral malaria should be suspected in cases of seizures accompanying malaria, and treatment should be initiated in the ICU. Furthermore, resistance of P. falciparum to artemisinin should be in mind when a response to therapy is lacking.
由于全球化的加剧,疟疾这种寄生虫病开始在全球范围内的重症监护病房(ICU)中出现。由恶性疟原虫引起的严重疟疾,其特征包括脑型疟疾、急性肾衰竭、低血糖、严重贫血、脾肿大和肺泡水肿。我们报告一例25岁男性患者,2014年冬季因发热三天就诊于土耳其布尔萨乌鲁达大学急诊科。他的病史显示曾在坦桑尼亚停留14个月。血液涂片染色显示符合恶性疟原虫感染的特征性配子体。入院次日,他发生癫痫发作,之后格拉斯哥昏迷量表评分为6分,因此进行气管插管并转入ICU。计算机断层扫描显示脑水肿的表现。静脉注射甘露醇6天。静脉注射青蒿素持续10天。由于发热难治,在第14天抗疟治疗改为奎宁和强力霉素,第16天发热停止。该病例强调,疟疾伴发癫痫发作时应怀疑脑型疟疾,且应在ICU开始治疗。此外,当治疗缺乏反应时,应考虑恶性疟原虫对青蒿素的耐药性。